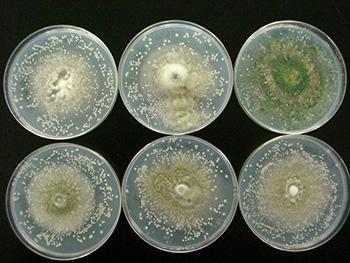

油井 信弘(化学微生物学研究室)





藤井 克彦(生物資源化学研究室)





飯島 陽子(食品化学研究室)




後関 頼太(有機高分子化学研究室)




小林 元康( 有機高分子化学研究室)



杉山 健二郎(食品化学研究室)




酒井 裕司(環境修復工学研究室)



小林 潤(環境熱工学研究室)





高木 亮(電気鉄道システム研究室)





遠藤 新(都市デザイン 遠藤新 研究室)





篠沢 健太(ランドスケープデザイン 篠沢研究室)





戸村 英子(ランドスケープデザイン 戸村研究室)





野澤 康(都市デザイン 野澤研究室)




岩村 雅人(建築生産 岩村研究室)





鈴木 賢人(建築構造 鈴木賢人研究室)



田村 雅紀(建築生産 田村研究室)